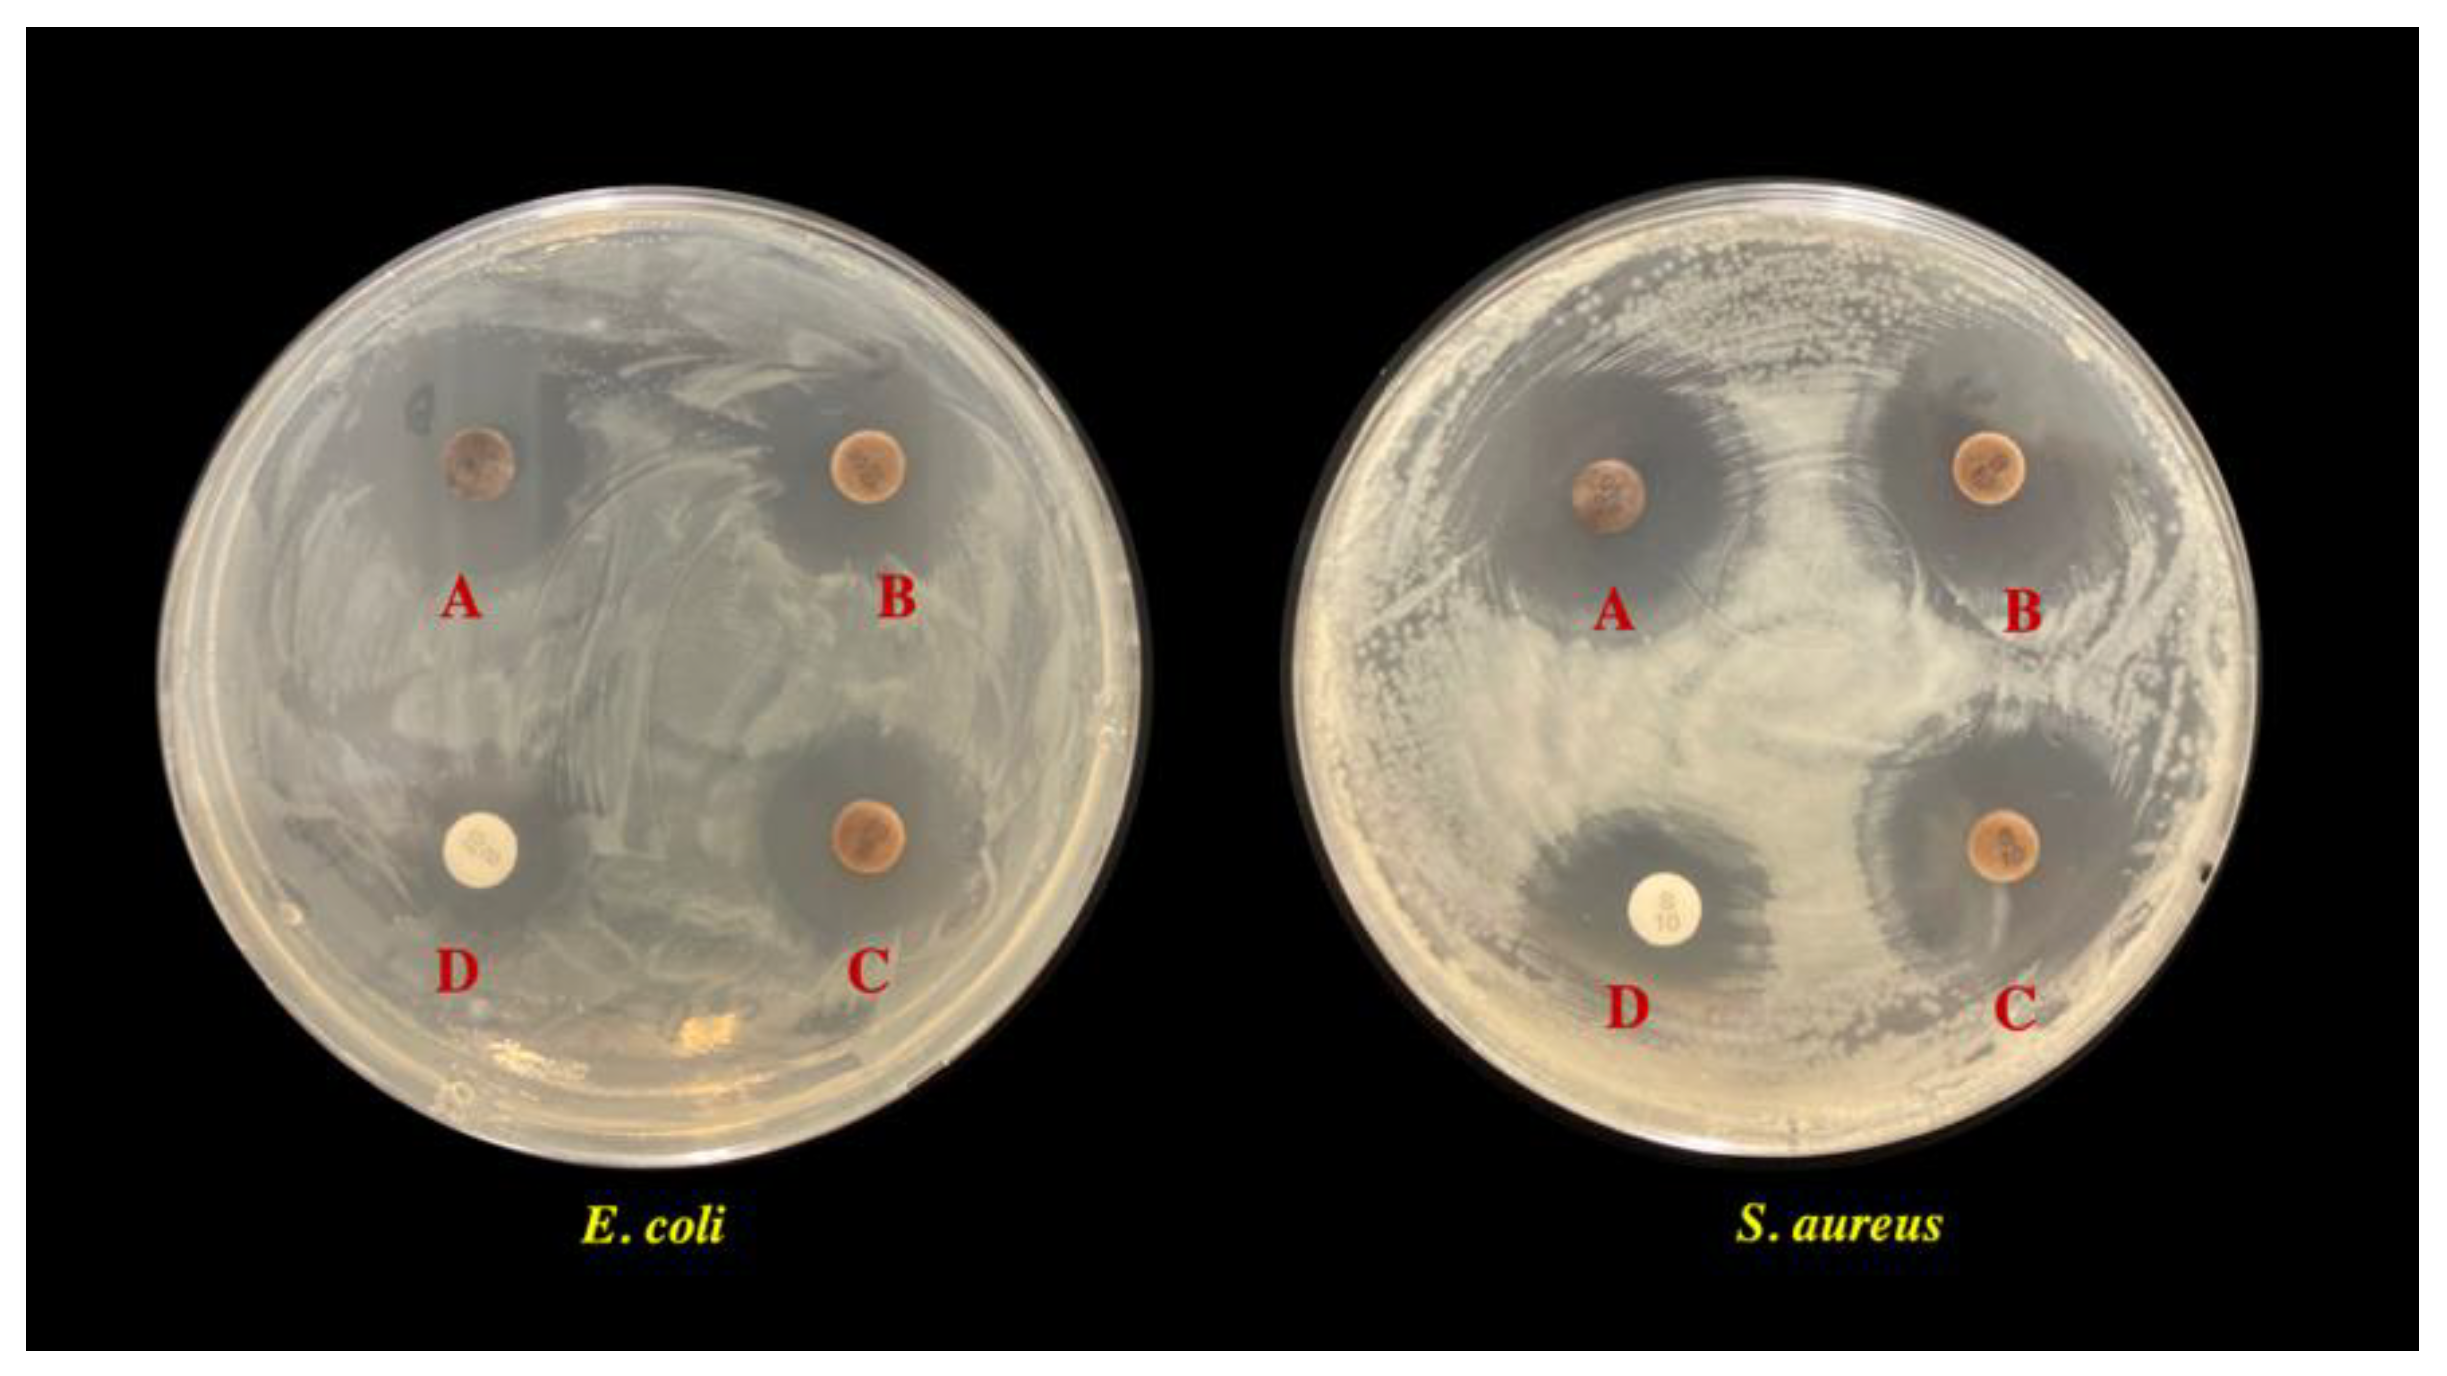
Polymers 14 03140 g008

Light-Emitting-Diode-Assisted, Fungal-Pigment-Mediated Biosynthesis of Silver Nanoparticles and Their Antibacterial Activity
Abstract
:1. Introduction
2. Materials and Methods
2.1. Chemicals
2.2. Fungal Extracellular Pigment Production and Extraction
2.3. Effect of Different Light Wavelengths on AgNP Biosynthesis
2.4. Optimization of Metal Salt Concentration and Time Course Study for AgNP Biosynthesis
2.5. AgNP Characterization
2.6. Antimicrobial Activity of Biosynthesized AgNPs
3. Results and Discussion
3.1. Effect of Different Light Wavelengths on AgNP Biosynthesis
3.2. Optimization of Precursor Concentration for AgNP Biosynthesis
3.3. Time Course Study of AgNP Biosynthesis
3.4. AgNP Characterization
3.5. Antimicrobial Activity
4. Conclusions
Supplementary Materials
Author Contributions
Funding
Institutional Review Board Statement
Informed Consent Statement
Data Availability Statement
Acknowledgments
Conflicts of Interest
References
- Abid, N.; Khan, A.M.; Shujait, S.; Chaudhary, K.; Ikram, M.; Imran, M.; Haider, J.; Khan, M.; Khan, Q.; Maqbool, M. Synthesis of nanomaterials using various top-down and bottom-up approaches, influencing factors, advantages, and disadvantages: A review. Adv. Colloid Interface Sci. 2022, 300, 102597. [Google Scholar] [CrossRef] [PubMed]
- Gautam, A.; Komal, P.; Gautam, P.; Sharma, A.; Kumar, N.; Jung, J.P. Recent trends in noble metal nanoparticles for colorimetric chemical sensing and micro-electronic packaging applications. Metals 2021, 11, 329. [Google Scholar] [CrossRef]
- Jin, R. The impacts of nanotechnology on catalysis by precious metal nanoparticles. Nanotechnol. Rev. 2012, 1, 31–56. [Google Scholar] [CrossRef]
- Giannossa, L.C.; Longano, D.; Ditaranto, N.; Nitti, M.A.; Paladini, M.P.F.; Rai, M.; Sannino, A.; Valentini, A.; Cioffi, N. Metal nanoantimicrobials for textile applications. Nanotechnol. Rev. 2013, 2, 307–331. [Google Scholar] [CrossRef]
- Conde, J.; Doria, G.; Baptista, P. Noble metal nanoparticles applications in cancer. J. Drug Deliv. 2012, 2012, 751075. [Google Scholar] [CrossRef]
- Yamada, M.; Foote, M.; Prow, T.W. Therapeutic gold, silver, and platinum nanoparticles. Wiley Interdiscip Rev. Nanomed. Nanobiotechnol. 2015, 7, 428–445. [Google Scholar] [CrossRef]
- Arshad, H.; Saleem, M.; Pasha, U.; Sadaf, S. Synthesis of aloe vera-conjugated silver nanoparticles for use against multidrug-resistant microorganisms. Electron. J. Biotechnol. 2022, 55, 55–64. [Google Scholar] [CrossRef]
- Masungaa, N.; Mmelesia, O.K.; Kefenia, K.K.; Mambaa, B.B. Recent advances in copper ferrite nanoparticles and nanocomposites T synthesis, magnetic properties and application in water treatment: Review. J. Environ. Chem. Eng. 2019, 7, 103179. [Google Scholar] [CrossRef]
- Kim, J.; Van der Bruggen, B. The use of nanoparticles in polymeric and ceramic membrane structures: Review of manufacturing procedures and performance improvement for water treatment. Environ. Pollut. 2010, 158, 2335–2349. [Google Scholar] [CrossRef] [PubMed]
- Jo, Y.-K.; Cromwell, W.; Jeong, H.-K.; Thorkelson, J.; Roh, J.-H.; Shin, D.-B. Use of silver nanoparticles for managing Gibberella fujikuroi on rice seedlings. Crop Prot. 2015, 74, 65–69. [Google Scholar] [CrossRef]
- Nayantaraa; Kaurb, P. Biosynthesis of nanoparticles using eco-friendly factories and their role in plant pathogenicity: A review. Biotechnol. Res. Innov. 2018, 2, 63–73. [Google Scholar] [CrossRef]
- Morones, J.R.; Elechiguerra, J.L.; Camacho, A.; Holt, K.; Kouri, J.B.; Ramirez, J.T.; Yacaman, M.J. The bactericidal effect of silver nanoparticles. Nanotechnology 2005, 16, 2346–2353. [Google Scholar] [CrossRef] [Green Version]
- Singh, P.; Kim, Y.J.; Zhang, D.; Yang, D.C. Biological synthesis of nanoparticles from plants and microorganisms. Trends Biotechnol. 2016, 34, 588–599. [Google Scholar] [CrossRef]
- Makarov, V.V.; Love, A.J.; Sinitsyna, O.V.; Makarova, S.S.; Yaminsky, I.V.; Taliansky, M.E.; Kalinina, N.O. Green nanotechnologies synthesis of metal nanoparticles using plants. Acta Nat. 2014, 6, 35–44. [Google Scholar] [CrossRef] [Green Version]
- Osibe, D.A.; Chiejina, N.V.; Ogawa, K.; Aoyagi, H. Stable antibacterial silver nanoparticles produced with seed-derived callus extract of Catharanthus roseus. Artif. Cells Nanomed. Biotechnol. 2018, 46, 1266–1273. [Google Scholar] [CrossRef] [Green Version]
- Mandal, D.; Bolander, M.E.; Mukhopadhyay, D.; Sarkar, G.; Mukherjee, P. The use of microorganisms for the formation of metal nanoparticles and their application. Appl. Microbiol. Biotechnol. 2006, 69, 485–492. [Google Scholar] [CrossRef]
- Siddiqi, K.S.; Husen, A.; Rao, R.A.K. A review on biosynthesis of silver nanoparticles and their biocidal properties. J. Nanobiotechnology 2018, 16, 14. [Google Scholar] [CrossRef]
- Bhatnagar, S.; Kobori, T.; Ganesh, D.; Ogawa, K.; Aoyagi, H. Biosynthesis of silver nanoparticles mediated by extracellular pigment from Talaromyces purpurogenus and their biomedical applications. Nanomaterials 2019, 9, 1042. [Google Scholar] [CrossRef] [Green Version]
- Neethu, S.; Midhun, S.J.; Sunil, M.A.; Soumya, S.; Radhakrishnan, E.K.; Jyothis, M. Efficient visible light induced synthesis of silver nanoparticles by Penicillium polonicum ARA 10 isolated from Chetomorpha antennina and its antibacterial efficacy against Salmonella enterica serovar Typhimurium. J. Photochem. Photobiol. B 2018, 180, 175–185. [Google Scholar] [CrossRef]
- Thatoi, P.; Kerry, R.G.; Gouda, S.; Das, G.; Pramanik, K.; Thatoi, H.; Patra, J.K. Photo-mediated green synthesis of silver and zinc oxide nanoparticles using aqueous extracts of two mangrove plant species, Heritiera fomes and Sonneratia apetala and investigation of their biomedical applications. J. Photochem. Photobiol. B 2016, 163, 311–318. [Google Scholar] [CrossRef]
- Rahman, A.; Kumar, S.; Bafana, A.; Lin, J.; Dahoumane, S.A.; Jeffryes, C. A mechanistic view of the light-induced synthesis of silver nanoparticles using extracellular polymeric substances of Chlamydomonas reinhardtii. Molecules 2019, 24, 3506. [Google Scholar] [CrossRef] [PubMed] [Green Version]
- Du, L.; Xu, Q.; Huang, M.; Xian, L.; Feng, J.-X. Synthesis of small silver nanoparticles under light radiation by fungus Penicillium oxalicum and its application for the catalytic reduction of methylene blue. Mater. Chem. Phys. 2015, 160, 40–47. [Google Scholar] [CrossRef]
- Bhat, R.; Deshpande, R.; Ganachari, S.V.; Huh, D.S.; Venkataraman, A. Photo-irradiated biosynthesis of silver nanoparticles using edible mushroom Pleurotus florida and their antibacterial activity studies. Bioinorg. Chem. Appl. 2011, 2011, 650979. [Google Scholar] [CrossRef] [PubMed] [Green Version]
- Anh, M.N.T.; Nguyen, D.T.D.; Thanh, N.V.K.; Phong, N.T.P.; Nguyen, D.H.; Nguyen-Le, M.-T. Photochemical synthesis of silver nanodecahedrons under blue LED irradiation and their SERS activity. Processes 2020, 8, 292. [Google Scholar] [CrossRef] [Green Version]
- Stamplecoskie, K.G.; Scaiano, J.C. Light emitting diode irradiation can control the morphology and optical properties of silver nanoparticles. J. Am. Chem. Soc. 2010, 132, 1825–1827. [Google Scholar] [CrossRef]
- Dufossé, L. Red colourants from filamentous fungi: Are they ready for the food industry? J. Food Compos. Anal. 2018, 69, 156–161. [Google Scholar] [CrossRef]
- Pandit, S.G.; Puttananjaih, M.H.; Harohally, N.V.; Dhale, M.A. Functional attributes of a new molecule-2-hydroxymethyl-benzoic acid 2′-hydroxy-tetradecyl ester isolated from Talaromyces purpureogenus CFRM02. Food Chem. 2018, 255, 89–96. [Google Scholar] [CrossRef]
- Bhatnagar, S.; Ogbonna, C.N.; Ogbonna, J.C.; Aoyagi, H. Effect of physicochemical factors on extracellular fungal pigment-mediated biofabrication of silver nanoparticles. Green. Chem. Lett. Rev. 2022, 15, 276–286. [Google Scholar] [CrossRef]
- Sritong, N.; Chumsook, S.; Siri, S. Light emitting diode irradiation induced shape conversion of DNA-capped silver nanoparticles and their antioxidant and antibacterial activities. Artif. Cells Nanomed. Biotechnol. 2018, 46, 955–963. [Google Scholar] [CrossRef] [Green Version]
- Lalpuria, M.; Karwa, V.; Anantheswaran, R.C.; Floros, J.D. Modified agar diffusion bioassay for better quantification of Nisaplin. J. Appl. Microbiol. 2012, 114, 663–671. [Google Scholar] [CrossRef]
- Wan, G.; Ruan, L.; Yin, Y.; Yang, T.; Ge, M.; Cheng, X. Effects of silver nanoparticles in combination with antibiotics on the resistant bacteria Acinetobacter baumannii. Int. J. Nanomed. 2016, 11, 3789–3800. [Google Scholar] [CrossRef] [Green Version]
- Kumar, V.; Mohan, S.; Singh, D.K.; Verma, D.K.; Singh, V.K.; Hasan, S.H. Photo-mediated optimized synthesis of silver nanoparticles for the selective detection of Iron (III), antibacterial and antioxidant activity. Mater. Sci. Eng. C Mater. Biol. Appl. 2017, 71, 1004–1019. [Google Scholar] [CrossRef]
- Sharma, A.; Sagar, A.; Rana, J.; Rani, R. Green synthesis of silver nanoparticles and its antibacterial activity using fungus Talaromyces purpureogenus isolated from Taxus baccata Linn. Micro Nano Syst. Lett. 2022, 10, 2. [Google Scholar] [CrossRef]
- Lee, J.H.; Lim, J.M.; Velmurugan, P.; Park, Y.J.; Park, Y.J.; Bang, K.S.; Oh, B.T. Photobiologic-mediated fabrication of silver nanoparticles with antibacterial activity. J. Photochem. Photobiol. B 2016, 162, 93–99. [Google Scholar] [CrossRef]
- Kumar, V.; Gundampati, R.K.; Singh, D.K.; Jagannadham, M.V.; Sundar, S.; Hasan, S.H. Photo-induced rapid biosynthesis of silver nanoparticle using aqueous extract of Xanthium strumarium and its antibacterial and antileishmanial activity. J. Ind. Eng. Chem. 2016, 37, 224–236. [Google Scholar] [CrossRef]
- Patra, J.K.; Das, G.; Baek, K.H. Phyto-mediated biosynthesis of silver nanoparticles using the rind extract of watermelon (Citrullus lanatus) under photo-catalyzed condition and investigation of its antibacterial, anticandidal and antioxidant efficacy. J. Photochem. Photobiol. B 2016, 161, 200–210. [Google Scholar] [CrossRef]
- Patra, J.K.; Das, G.; Kumar, A.; Ansari, A.; Kim, H.; Shin, H.S. Photo-mediated biosynthesis of silver nanoparticles using the non-edible accrescent fruiting calyx of Physalis peruviana L. fruits and investigation of its radical scavenging potential and cytotoxicity activities. J. Photochem. Photobiol. B 2018, 188, 116–125. [Google Scholar] [CrossRef]
- Dhivahar, J.; Khusro, A.; Elancheran, L.; Agastian, P.; Al-Dhabi, N.A.; Esmail, G.A.; Arasu, M.V.; Kim, Y.O.; Kim, H.; Kim, H.-J. Photo-mediated biosynthesis and characterization of silver nanoparticles using bacterial xylanases as reductant: Role of synthesized product (Xyl-AgNPs) in fruits juice clarification. Surf. Interfaces 2020, 21, 100747. [Google Scholar] [CrossRef]
- Bao, Z.; Lan, C.Q. Mechanism of light-dependent biosynthesis of silver nanoparticles mediated by cell extract of Neochloris oleoabundans. Colloids Surf. B Biointerfaces 2018, 170, 251–257. [Google Scholar] [CrossRef]
- Bao, Z.; Cao, J.; Kang, G.; Lan, C.Q. Effects of reaction conditions on light-dependent silver nanoparticle biosynthesis mediated by cell extract of green alga Neochloris oleoabundans. Environ. Sci. Pollut. Res. Int. 2019, 26, 2873–2881. [Google Scholar] [CrossRef]
- Sakamoto, M.; Fujistuka, M.; Majima, T. Light as a construction tool of metal nanoparticles: Synthesis and mechanism. J. Photochem. Photobiol. C Photochem. Rev. 2009, 10, 33–56. [Google Scholar] [CrossRef]
- Kumar, B.; Angulo, Y.; Smita, K.; Cumbal, L.; Debut, A. Capuli cherry-mediated green synthesis of silver nanoparticles under white solar and blue LED light. Particuology 2016, 24, 123–128. [Google Scholar] [CrossRef]
- Prathna, T.C.; Chandrasekaran, N.; Raichur, A.M.; Mukherjee, A. Biomimetic synthesis of silver nanoparticles by Citrus limon (lemon) aqueous extract and theoretical prediction of particle size. Colloids Surf. B Biointerfaces 2011, 82, 152–159. [Google Scholar] [CrossRef]
- Steinigeweg, D.; Schlucke, S. Monodispersity and size control in the synthesis of 20–100 nm quasi-spherical silver nanoparticles by citrate and ascorbic acid reduction in glycerol–water mixtures. Chem. Commun. 2012, 48, 8682–8784. [Google Scholar] [CrossRef] [Green Version]
- Mokhtari, N.; Daneshpajouh, S.; Seyedbagheri, S.; Atashdehghan, R.; Abdi, K.; Sarkar, S.; Minaian, S.; Shahverdi, H.R.; Shahverdi, A.R. Biological synthesis of very small silver nanoparticles by culture supernatant of Klebsiella pneumonia: The effects of visible-light irradiation and the liquid mixing process. Mater. Res. Bull. 2009, 44, 1415–1421. [Google Scholar] [CrossRef]
- Devadiga, A.; Shetty, K.V.; Saidutta, M.B. Highly stable silver nanoparticles synthesized using Terminalia catappa leaves as antibacterial agent and colorimetric mercury sensor. Mater. Lett. 2017, 207, 66–71. [Google Scholar] [CrossRef]
- Saeb, A.T.M.; Alshammari, A.S.; Al-Brahim, H.; Al-Rubeaan, K.A. Production of silver nanoparticles with strong and stable antimicrobial activity against highly pathogenic and multidrug resistant bacteria. Sci. World J. 2014, 2014, 704708. [Google Scholar] [CrossRef]
- Chutrakulwong, F.; Thamaphat, K.; Limsuwan, P. Photo-irradiation induced green synthesis of highly stable silver nanoparticles using durian rind biomass: Effects of light intensity, exposure time and pH on silver nanoparticles formation. J. Phys. Commun. 2020, 4, 095015. [Google Scholar] [CrossRef]
- Zhang, X.F.; Liu, Z.G.; Shen, W.; Gurunathan, S. Silver nanoparticles: Synthesis, characterization, properties, applications, and therapeutic approaches. Int. J. Mol. Sci. 2016, 17, 1534. [Google Scholar] [CrossRef]
- Erjaee, H.; Rajaian, H.; Nazifi, S. Synthesis and characterization of novel silver nanoparticles using Chamaemelum nobile extract for antibacterial application. Adv. Nat. Sci. Nanosci. Nanotechnol. 2017, 8, 025004. [Google Scholar] [CrossRef]
- Parul; Thiyam, G.; Dufossé, L.; Sharma, A.K. Characterization of Talaromyces purpureogenus strain F extrolites and development of production medium for extracellular pigments enriched with antioxidant properties. Food Bioprod. Process. 2020, 124, 143–158. [Google Scholar] [CrossRef]
- Singhal, G.; Bhavesh, R.; Kasariya, K.; Sharma, A.R.; Singh, R.P. Biosynthesis of silver nanoparticles using Ocimum sanctum (Tulsi) leaf extract and screening its antimicrobial activity. J. Nanoparticle Res. 2011, 13, 2981–2988. [Google Scholar] [CrossRef]
- Burt, S. Essential oils: Their antibacterial properties and potential applications in foods--a review. Int. J. Food Microbiol. 2004, 94, 223–253. [Google Scholar] [CrossRef] [PubMed]
- Loo, Y.Y.; Rukayadi, Y.; Nor-Khaizura, M.A.; Kuan, C.H.; Chieng, B.W.; Nishibuchi, M.; Radu, S. In Vitro Antimicrobial Activity of Green Synthesized Silver Nanoparticles Against Selected Gram-negative Foodborne Pathogens. Front. Microbiol. 2018, 9, 1555. [Google Scholar] [CrossRef]
- Balouiri, M.; Sadiki, M.; Ibnsouda, S.K. Methods for in vitro evaluating antimicrobial activity: A review. J. Pharm. Anal. 2016, 6, 71–79. [Google Scholar] [CrossRef] [Green Version]
- Hoseinzadeh, E.; Makhdoumi, P.; Taha, P.; Hossini, H.; Pirsaheb, M.; Rastegar, S.O.; Stelling, J. A review of available techniques for determination of nano-antimicrobials activity. Toxin Rev. 2016, 36, 18–32. [Google Scholar] [CrossRef]
- Lee, H.J.; Lee, S.G.; Oh, E.J.; Chung, H.Y.; Han, S.I.; Kim, E.J.; Seo, S.Y.; Ghim, H.D.; Yeum, J.H.; Choi, J.H. Antimicrobial polyethyleneimine-silver nanoparticles in a stable colloidal dispersion. Colloids Surf. B Biointerfaces 2011, 88, 505–511. [Google Scholar] [CrossRef]
- Gomaa, E.Z. Silver nanoparticles as an antimicrobial agent: A case study on Staphylococcus aureus and Escherichia coli as models for gram-positive and gram-negative bacteria. J. Gen. Appl. Microbiol. 2017, 63, 36–43. [Google Scholar] [CrossRef] [Green Version]
- Sanchez-Navarro, M.D.C.; Ruiz-Torres, C.A.; Nino-Martinez, N.; Sanchez-Sanchez, R.; Martinez-Castanon, G.A.; De Alba-Montero, I.; Ruiz, F. Cytotoxic and bactericidal effect of silver nanoparticles obtained by green synthesis method using Annona muricata aqueous extract and functionalized with 5-Fluorouracil. Bioinorg. Chem. Appl. 2018, 2018, 6506381. [Google Scholar] [CrossRef] [Green Version]
- Rajoka, M.S.R.; Mehwish, H.M.; Zhang, H.; Ashraf, M.; Fang, H.; Zeng, X.; Wu, Y.; Khurshid, M.; Zhao, L.; He, Z. Antibacterial and antioxidant activity of exopolysaccharide mediated silver nanoparticle synthesized by Lactobacillus brevis isolated from Chinese koumiss. Colloids Surf. B Biointerfaces 2020, 186, 110734. [Google Scholar] [CrossRef]
- Vanitha, G.; Rajavel, K.; Boopathy, G.; Veeravazhuthi, V.; Neelamegam, P. Physiochemical charge stabilization of silver nanoparticles and its antibacterial applications. Chem. Phys. Lett. 2017, 669, 71–79. [Google Scholar] [CrossRef]
- Thammawithan, S.; Siritongsuk, P.; Nasompag, S.; Daduang, S.; Klaynongsruang, S.; Prapasarakul, N.; Patramanon, R. A Biological Study of Anisotropic Silver Nanoparticles and Their Antimicrobial Application for Topical Use. Vet. Sci. 2021, 8, 177. [Google Scholar] [CrossRef]
- Wypij, M.; Czarnecka, J.; Swiecimska, M.; Dahm, H.; Rai, M.; Golinska, P. Synthesis, characterization and evaluation of antimicrobial and cytotoxic activities of biogenic silver nanoparticles synthesized from Streptomyces xinghaiensis OF1 strain. World J. Microbiol. Biotechnol. 2018, 34, 23. [Google Scholar] [CrossRef] [Green Version]
- Fayaz, A.M.; Balaji, K.; Girilal, M.; Yadav, R.; Kalaichelvan, P.T.; Venketesan, R. Biogenic synthesis of silver nanoparticles and their synergistic effect with antibiotics: A study against gram-positive and gram-negative bacteria. Nanomedicine 2010, 6, 103–109. [Google Scholar] [CrossRef]
- Patra, J.K.; Baek, K.H. Antibacterial activity and synergistic antibacterial potential of biosynthesized silver nanoparticles against foodborne pathogenic bacteria along with its anticandidal and antioxidant effects. Front. Microbiol. 2017, 8, 167. [Google Scholar] [CrossRef] [Green Version]
- Hafez, E.H.A.; Ahmed, E.A.; Abbas, H.S.; Di, R.A.S.E. Efficacy of antibiotics combined with biosynthesized silver nanoparticles on some pathogenic bacteria. Int. J. Sci. Res. 2017, 6, 1294–1303. [Google Scholar] [CrossRef]
- Ghaffar, N.; Javad, S.; Farrukh, M.A.; Shah, A.A.; Gatasheh, M.K.; Al-Munqedhi, B.M.A.; Chaudhry, O. Metal nanoparticles assisted revival of Streptomycin against MDRS Staphylococcus aureus. PLoS ONE 2022, 17, e0264588. [Google Scholar] [CrossRef]
- Slavin, Y.N.; Asnis, J.; Hafeli, U.O.; Bach, H. Metal nanoparticles: Understanding the mechanisms behind antibacterial activity. J. Nanobiotechnol. 2017, 15, 65. [Google Scholar] [CrossRef]
- Germovsek, E.; Barker, C.I.; Sharland, M. What do I need to know about aminoglycoside antibiotics? Arch. Dis. Child.-Educ. Pract. 2017, 102, 89–93. [Google Scholar] [CrossRef] [Green Version]
- Ball, A.P.; Gray, J.A.; Murdoch, J.M. Antibacterial Drugs today: II. Drugs 1975, 10, 81–111. [Google Scholar] [CrossRef]
- Ahmad, S.A.; Das, S.S.; Khatoon, A.; Ansari, M.T.; Afzal, M.; Hasnain, M.S.; Nayak, A.K. Bactericidal activity of silver nanoparticles: A mechanistic review. Mater. Sci. Enegy Technol. 2020, 3, 756–769. [Google Scholar] [CrossRef]
- Yuan, Y.G.; Peng, Q.L.; Gurunathan, S. Effects of silver nanoparticles on multiple drug-resistant strains of Staphylococcus aureus and Pseudomonas aeruginosa from mastitis-infected goats: An alternative approach for antimicrobial therapy. Int. J. Mol. Sci. 2017, 18, 569. [Google Scholar] [CrossRef] [Green Version]
- Cavassin, E.D.; de Figueiredo, L.F.; Otoch, J.P.; Seckler, M.M.; de Oliveira, R.A.; Franco, F.F.; Marangoni, V.S.; Zucolotto, V.; Levin, A.S.; Costa, S.F. Comparison of methods to detect the in vitro activity of silver nanoparticles (AgNP) against multidrug resistant bacteria. J. Nanobiotechnol. 2015, 13, 64. [Google Scholar] [CrossRef]

| Light Source | Maximum Wavelength | Maximum Absorbance (Amax) |
|---|---|---|
| Blue LEDs | 413 nm | 0.432 ± 0.010 |
| Green LEDs | 415 nm | 0.373 ± 0.001 |
| Orange LEDs | 430 nm | 0.231 ± 0.003 |
| Red LEDs | 415 nm | 0.222 ± 0.002 |
| Infrared LEDs | 411 nm | 0.347 ± 0.001 |
| White light | 409 nm | 0.180 ± 0.001 |
| Dark | 415 nm | 0.157 ± 0.002 |
| Biosynthesized AgNPs | Zeta Potential (mV) |
|---|---|
| AgNPs-Blue LED | −40.60 ± 1.49 |
| AgNPs-Green LED | −47.90 ± 1.19 |
| AgNPs-Infrared LED | −44.40 ± 0.78 |
| Frequency Range (cm−1) | Functional Group | Treatment | |||
|---|---|---|---|---|---|
| Pigment pH 10 | AgNPs-Blue LED | AgNPs-Green LED | AgNPs-Infrared LED | ||
| 3570–3200 | H, OH, hydroxyl group | + | + | + | + |
| 3000–2840 | C–H alkane | + | - | - | - |
| 1730–1715 | C=O group ester | + | - | - | - |
| 1650–1600 | NH amide group | + | + | + | + |
| 1390–1310 | OH bending phenol | + | + | + | + |
| Bacterial Strain | Antimicrobial Treatment | |||||||
|---|---|---|---|---|---|---|---|---|
| AgNPs-Blue LED | AgNPs-Green LED | AgNPs-Infrared LED | Streptomycin | |||||
| MIC | MBC | MIC | MBC | MIC | MBC | MIC | MBC | |
| E. coli | 125 | 125 | 62.50 | 62.50 | 62.50 | 125 | 15.62 | 31.25 |
| S. aureus | 125 | 125 | 62.50 | 125 | 62.50 | 125 | 15.62 | 31.25 |
| Bacterial Strain | Zone of Inhibition (mm) | ||||||
|---|---|---|---|---|---|---|---|
| Individual Treatment | Combined Treatment with Streptomycin | ||||||
| AgNPs-Blue LED | AgNPs-Green LED | AgNPs- Infrared LED | Streptomycin | AgNPs- Blue LED | AgNPs-Green LED | AgNPs- Infrared LED | |
| E. coli | 9 ± 0.89 | 10 ± 1.45 | 10 ± 0.58 | 12 ± 2.33 | 19 ± 0.67 | 20 ± 1.26 | 19 ± 0.67 |
| S. aureus | 9 ± 0.67 | 9 ± 1.0 | 8 ± 0.58 | 11 ± 1.67 | 20 ± 0.67 | 21 ± 0.58 | 21 ± 0.33 |
| Bacterial Strain | Equivalent Streptomycin Concentration (μg/mL) | |||||
|---|---|---|---|---|---|---|
| Sum of Individual Treatments (A + B) | Combined Treatment with Streptomycin (C) | |||||
| AgNPs- Blue LED | AgNPs- Green LED | AgNPs- Infrared LED | AgNPs-Blue LED | AgNPs-Green LED | AgNPs- Infrared LED | |
| E. coli | 15 ± 2.43 | 16 ± 4.19 | 15 ± 2.59 | 62 ± 5.25 | 89 ± 17.89 | 62 ± 5.25 |
| S. aureus | 21 ± 5.23 | 22 ± 5.97 | 21 ± 5.22 | 97 ± 12.24 | 141 ± 21.90 | 97 ± 12.24 |
| Combined Treatment with Streptomycin | Bacterial Strains | |||
|---|---|---|---|---|
| E. coli | S. aureus | |||
| FIC Index | Nature of Interaction | FIC Index | Nature of Interaction | |
| AgNPs-Blue LED | 0.26 ± 0.04 | Synergistic | 0.25 ± 0.04 | Synergistic |
| AgNPs-Green LED | 0.24 ± 0.05 | Synergistic | 0.22 ± 0.05 | Synergistic |
| AgNPs-Infrared LED | 0.38 | Synergistic | 0.26 ± 0.01 | Synergistic |
Publisher’s Note: MDPI stays neutral with regard to jurisdictional claims in published maps and institutional affiliations. |
© 2022 by the authors. Licensee MDPI, Basel, Switzerland. This article is an open access article distributed under the terms and conditions of the Creative Commons Attribution (CC BY) license (https://creativecommons.org/licenses/by/4.0/).
Share and Cite
Nuanaon, N.; Bhatnagar, S.; Motoike, T.; Aoyagi, H. Light-Emitting-Diode-Assisted, Fungal-Pigment-Mediated Biosynthesis of Silver Nanoparticles and Their Antibacterial Activity. Polymers 2022, 14, 3140. https://doi.org/10.3390/polym14153140
Nuanaon N, Bhatnagar S, Motoike T, Aoyagi H. Light-Emitting-Diode-Assisted, Fungal-Pigment-Mediated Biosynthesis of Silver Nanoparticles and Their Antibacterial Activity. Polymers. 2022; 14(15):3140. https://doi.org/10.3390/polym14153140
Chicago/Turabian StyleNuanaon, Nobchulee, Sharad Bhatnagar, Tatsuya Motoike, and Hideki Aoyagi. 2022. "Light-Emitting-Diode-Assisted, Fungal-Pigment-Mediated Biosynthesis of Silver Nanoparticles and Their Antibacterial Activity" Polymers 14, no. 15: 3140. https://doi.org/10.3390/polym14153140
APA StyleNuanaon, N., Bhatnagar, S., Motoike, T., & Aoyagi, H. (2022). Light-Emitting-Diode-Assisted, Fungal-Pigment-Mediated Biosynthesis of Silver Nanoparticles and Their Antibacterial Activity. Polymers, 14(15), 3140. https://doi.org/10.3390/polym14153140

